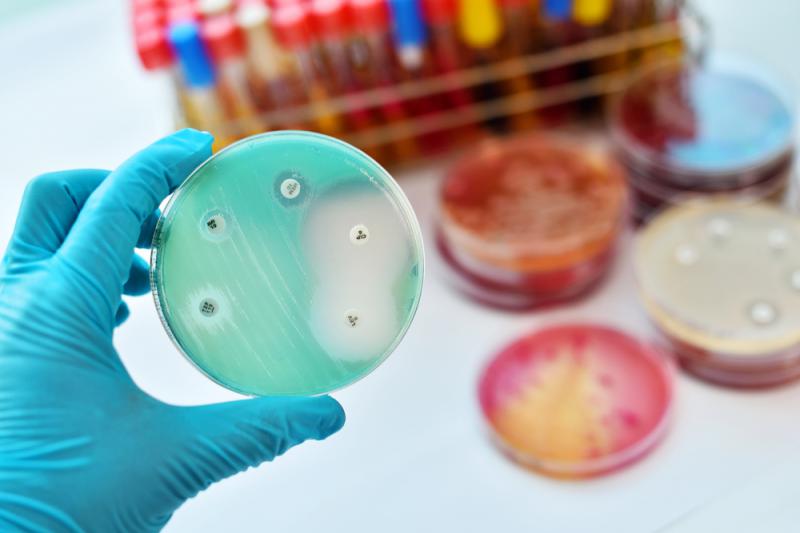

Gronkowiec – objawy, rodzaje i leczenie gronkowca
Gronkowiec złocisty jest dziś postrachem szpitali na całym świecie. Ta niezwykle zjadliwa bakteria należy do szerszego grona mikrobów szczególnie nieprzyjaznych zdrowiu ludzkiemu. Co możemy więc zrobić we własnym zakresie, aby zminimalizować ryzyko zakażeniem gronkowcami?

Po raz pierwszy gronkowca opisał w 1880 r. szkocki chirurg Sir Alexander Ogston, który wykrył bakterię w ropie pobranej z ropnia w kolanie pacjenta. To on też ukuł łacińską nazwę rodzajową Staphylococcus, łącząc greckie słowo „staphylo” oznaczające kiść winogron z członem „coccus” odnoszącym się do sferycznych bakterii. W 1884 r. niemiecki lekarz, Friedrich Julius Rosenbach, zaczął dalej klasyfikować różne gatunki gronkowców inspirując się kolorami ich kolonii widzianych pod mikroskopem.
Gronkowce – co to za bakterie?
Pod względem biologicznym gronkowce, zwane również stafilokokami, to rodzaj złożony z przynajmniej czterdziestu różnych gatunków, z których część posiada dodatkowo podgatunki. Ich wspólną właściwością jest wspomniany wyżej groniasty wygląd dobrze widzialny pod mikroskopem. Pojedyncze komórki mają kształt sferyczny, ale zawsze formują większe skupiska. Poza tym oznacza się je jako gram-dodatnie ziarnkowce, a prawie wszystkie są również względnymi beztlenowcami, co oznacza, że potrafią się rozwijać bez dostępu tlenu, jak i w jego obecności.
Rodzaje gronkowców
Nie wszystkie gatunki gronkowców mają wpływ na ludzkie zdrowie. Do miana niechlubnego lidera pod tym względem pretenduje gronkowiec złocisty (Staphylococcus aureus), nazwany tak ze względu na złotą barwę swych kolonii. To on właśnie odpowiedzialny jest za szereg chorób, w tym stany groźne dla życia człowieka. Co ciekawe, jego normalnym środowiskiem jest skóra ludzi i zwierząt, a dodatkowo występuje również powszechnie w naszej jamie nosowo-gardłowej. Gronkowiec złocisty należy przy tym, do bakterii koagulazododatnich, co oznacza, że potrafi wytwarzać białkowy enzym odgrywający najprawdopodobniej ważną funkcję ochronną.
Poza tym w organizmie ludzkim występuje również gronkowiec skórny (S. epidermidis), zlokalizowany przede wszystkim na błonach śluzowych jamy ustnej, gardła i nosa, jak również na skórze, w jelitach oraz układzie moczowo-płciowym. Jest to bakteria znacznie mniej niebezpieczna niż gronkowiec złocisty, ale dla ludzi o obniżonej odporności może stanowić poważne zagrożenie. W drogach moczowych spotykany jest również gronkowiec saprofityczny (S. saprophyticus) i choć stanowi on naturalny element fizjologicznej mikroflory w sprzyjających warunkach może prowadzić do rozwoju infekcji.
Mniej znanym gatunkiem jest za to S. caprae, obserwowany przede wszystkim u kóz, ale wyhodowany również z próbek pobranych z człowieka, przede wszystkim w kontekście stanów zapalnych dróg moczowych, skóry, krwi, kości i stawów. Stosunkowo ważną częścią ludzkiej mikroflory jest ponadto S. haemolitycus, rezydujący przede wszystkim na skórze i powodujący szereg nieprzyjemnych infekcji. Ten ostatni gronkowiec posiada niezwykłą zdolność do wytwarzania własnego biofilmu, który czyni go odpornym na działanie wielu leków!
Dodajmy, że wraz z rozwojem medycyny i technik badawczych okazuje się, że coraz większa liczba gronkowców stwarza zagrożenie dla zdrowia ludzkiego i nie jest taka niewinna, jak się wcześniej zdawało.
Ciekawostka: Obecne na naszej skórze gronkowce odpowiedziane są za rozkładanie leucyny do kwasu izowalerianowego, co w rezultacie prowadzi do powstawania nieprzyjemnego zapachu stóp!
Choroby powodowane przez gronkowce
Pomimo zagrożeń związanych ze wspomnianymi wyżej gatunkami gronkowców, środowisko medyczne skupia się przede wszystkim na gronkowcu złocistym, jako największym nieprzyjacielu człowieka. Posiada on dość unikalną zdolność do produkowania toksyny, zwanej enterotoksyną, która znajdowana jest w produktach spożywczych, w których doszło do kolonizacji bakterii.
Co gorsza, chociaż wysoka temperatura zniszczy same gronkowce, entertoksyna pozostaje zwykle w żywności, powodując poważne zatrucia pokarmowe przebiegające z wymiotami i biegunką. Najczęściej źródłem toksyn gronkowcowych są zamrażane powtórnie lody, ale także przetwory mleczne, sałatki, wędliny, kremy, dania mięsne, a nawet ciastka.
Na kłopotach żołądkowych wrogość gronkowca złocistego się jednak nie kończy. Ta dość powszechna bakteria dość łatwo przenosi się bowiem między ludźmi i po kolonizacji może stać się źródłem infekcji. Podstawowe metody zakażenia obejmują drogę kropelkową (np. kichanie, kaszel), używanie wspólnych przedmiotów oraz kontakt pośredni. Szczególnie narażone są przy tym osoby z ranami otwartymi, ciałami obcymi utkwionymi w organizmie, jak również chorobami obniżającym odporność, np. leukemią czy cukrzycą.
Najczęściej zakażenia gronkowcem złocistym (i innymi gronkowcami) dotyczą skóry. Zjadliwe bakterie powodują m.in. ropnie, czyli wypełnione ropą torebki podskórne, którym towarzyszy zaczerwienienie i ból oraz cellulitis, groźną chorobę głębokich warstw skóry objawiającą się zaczerwieniem, opuchlizną i silnym bólem. Istnieje nawet jednostka chorobowa zwana gronkowcowym zespołem skóry oparzonej (inaczej zespół Rittera), która najczęściej doskwiera małym dzieciom i wiąże się z utratą naskórka.
Poza tym gronkowiec może powodować zapalenie płuc, a w jeszcze drastyczniejszych przypadkach przedostaje się do krwi wywołując m.in. bakteriemię, posocznicę, zapalenie mięśnia sercowego czy zapalenie opon mózgowo-rdzeniowych. Toksyny produkowane przez S. aureus bywają ponadto przyczyną zespołu wstrząsu toksycznego, groźnego dla życia stanu przebiegającego z wysoką gorączką, wymiotami, bólami mięśni i wysypką na dłoniach oraz stopach.
Czy gronkowce można zwalczać naturalnym sposobami?
Chociaż infekcje bakteryjne co do zasady leczy się antybiotykami istnieją również substancje naturalnego pochodzenia, które w warunkach laboratoryjnych wykazują skuteczność nawet wobec szczególnie zjadliwego gronkowca złocistego. Do najważniejszych należą:
- miód – badania wskazują, że skutecznie leczy rany zakażone S. aureus;
- olejki eteryczne z goździka i cynamonu;
- ekstrakty roślinny, m.in. tatarak zwyczajny, indyjska sarsaparila, herbata chińska, granat właściwy, liściokwiat garbnikowy, mangostan właściwy, bazylia eugenolowa, gorzknik kanadyjski i inne.
Wspomniane wyżej rośliny wykorzystywane są od wieków w medycynie ludowej do leczenia ran i innych infekcji, a ich skuteczność wynika przede wszystkim z zawartości aktywnych związków, takich jak beta-asarone, kemferol czy mansonone – naukowcy uczą się dziś izolować je w celu wykorzystania terapeutycznego.
Antybiotykoterapia w walce z gronkowcem
Niestety, większość infekcji wywołanych gronkowcem jest na tyle niebezpieczna, że wymaga jak najszybszego zaaplikowania stosownych antybiotyków. Do najczęściej stosowanych należą leki z grupy cefalosporyn, nafcylina lub oksacylina, wankomycyna, daptomycyna czy telwancyna. W przypadku infekcji skórnych konieczne może być chirurgiczne oczyszczenie / drenaż ran, a także stosowanie maści antybiotycznych. W przypadku zakażenia implantów konieczne jest ich wyjęcie!
Powszechne nadużycie antybiotyków doprowadziło już jednak do rozwoju odporności wśród łatwo adaptujących się gronkowców. Dla przykładu, penicylina jest dziś skuteczna jedynie w około 5% przypadków infekcji wywołanych przez bakterie z rodzaju Staphylococcus. Za szczególnie groźne uważna się dziś szczepy MRSA, czyli gronkowca złocistego odpornego na metycylinę oraz VRSA, czyli gronkowca złocistego odpornego na wankomycynę. Ten pierwszy jest dziś prawdziwą plagą szpitali, więzień oraz domów opieki – nawet 53 miliony ludzi na świecie są dziś jego nosicielami! W samych Stanach Zjednoczonych MRSA nabyty w szpitalu jest powodem ponad 11 tysięcy zgonów rocznie.
Jak uniknąć zakażenia gronkowcem?
Mimo że gronkowce występują powszechnie w naszych środowisku, a nawet na naszym ciele, można zrobić dużo, aby się chronić przed potencjalną infekcją. Za najważniejsze środki prewencji uważa się obecnie:
- częste mycie rąk przez okres minimum 20 sekund, w szczególności po kontakcie ze zwierzęcymi odchodami, surowym mięsem czy po wizycie w toalecie;
- dezynfekcja i przykrywanie wszystkich ran na ciele, nawet tych najmniejszych;
- ograniczenie używania tamponów na rzecz podpasek lub częste zmiany tamponów o mniejszej chłonności;
- nie dzielenie się rzeczami osobistymi typu ręczniki, żyletki, sprzęt sportowy, ubrania z innymi osobami;
- pranie pościeli i ubrań w wysokich temperaturach, jeśli to możliwe z dodatkiem wybielacza;
- utrzymywanie pożywienia w temperaturze powyżej 60 stopni C lub poniżej 4 stopni C.
Szczególną ostrożność należy zachować podczas wizyt w szpitalach i placówkach służby zdrowia, zwracając staranną uwagę na mycie rąk, dezynfekcję oraz zasłanianie ust i nosa. Niestety, według czarnych scenariuszy przy dotychczasowym nadużyciu antybiotyków gronkowce, zwłaszcza MRSA, mogą w przyszłości stać się częstą komplikacją nawet błahych hospitalizacji!

Absolwentka Wydziału Zarządzania Uniwersytetu Gdańskiego, która oddała się pasji zgłębiania zagadek świata i pisania o nich. Specjalizuje się w ekologii, klimatologii i naukach przyrodniczo-naukowych. Żyje ponad granicami, dużo podróżuje, a w wolnym czasie pływa.
Opublikowany: 13 sierpnia, 2021 | Zaktualizowany: 21 sierpnia, 2025
- Giancarlo Licitra; "Etymologia: Staphylococcus"; https://www.ncbi.nlm.nih.gov/pmc/articles/PMC3810938/; 2021-07-16;
- WebMD; "Staph Infection and Cellulitis"; 2021-07-16;
- APIC; "Staphylococcus aureus"; https://apic.org/monthly_alerts/staphylococcus-aureus/; 2021-07-16;
- Cleveland Clinic; "What Causes Staph Infections, and How Can You Avoid Them?"; https://health.clevelandclinic.org/staph-infections-what-are-they-and-when-should-you-worry/; 2021-07-16;
- Tracey A. Taylor; Chandrashekhar G. Unakal; "Staphylococcus Aureus"; https://www.ncbi.nlm.nih.gov/books/NBK441868/; 2021-07-16;
- Steven Y. C. Tong i in.; "Staphylococcus aureus Infections: Epidemiology, Pathophysiology, Clinical Manifestations, and Management"; https://www.ncbi.nlm.nih.gov/pmc/articles/PMC4451395/; 2021-07-16;
- Qing Liu i in.; "Antibacterial and Antifungal Activities of Spices"; https://www.ncbi.nlm.nih.gov/pmc/articles/PMC5486105/; 2021-07-16;